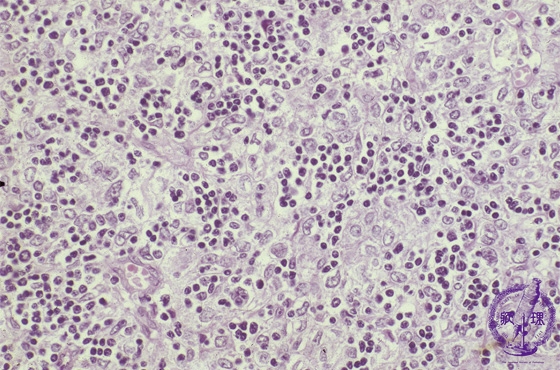

Microscopic view (high power view): WHO type B2 thymoma (mixed lymphocytic and epithelial thymoma). The number of tumor cells, distinguished by their large vesicular nuclei, is proportional to that of the non-neoplastic lymphocytes.
Click the image to see the enlarged image.